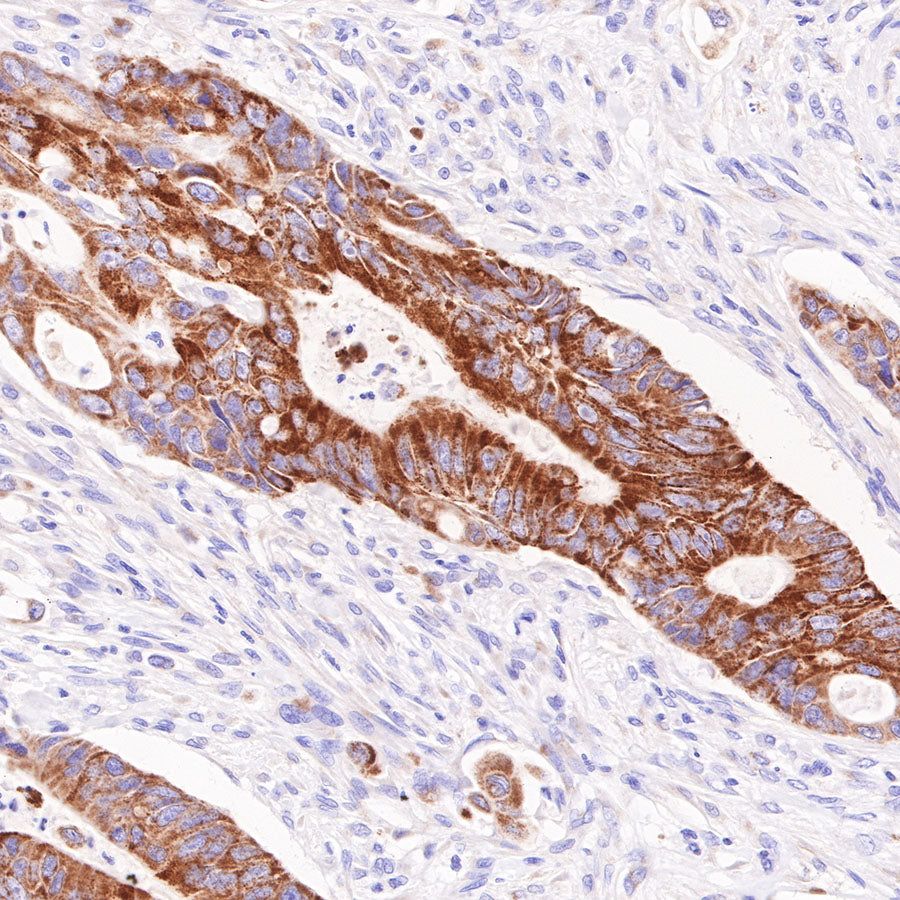
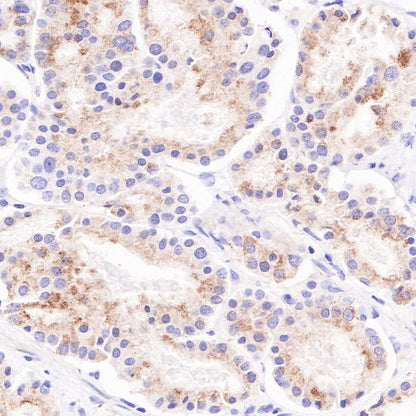

WB result of AMACR Rabbit mAb
Primary antibody: AMACR Rabbit mAb at 1/500 dilution
Lane 1: LNCaP whole cell lysate 20 µg
Secondary antibody: Goat Anti-Rabbit IgG, (H+L), HRP conjugated at 1/10000 dilution
Predicted MW: 42kDa
Observed MW: 42kDa
| Host | Rabbit |
| Antigen | AMACR/P504S |
| Synonyms | Alpha-methylacyl-CoA racemase, 2-methylacyl-CoA racemase |
| Immunogen | Synthetic Peptide |
| Location | Mitochondrion, Peroxisome |
| Accession | Q9UHK6 |
| Clone Number | SDT-401-29 |
| Antibody Type | Recombinant mAb |
| Application | WB, IHC-P, ICC, ICFCM |
| Reactivity | Hu, Ms |
| Purification | Protein A |
| Concentration | 0.25 mg/ml |
| Tag | N/A |
| Physical Appearance | Liquid |
| Storage Buffer | PBS, 40% Glycerol, 0.05% BSA, 0.03% Proclin 300 |
| Stability & Storage | 12 months from date of receipt / reconstitution, -20 °C as supplied |
| application | dilution | species |
| WB | 1:500 | |
| IHC-P | 1:1000 | |
| ICC | 1:250 | |
| ICFCM | 1:250 |
α-Methylacyl-CoA racemase (AMACR; P504S) catalyzes a key chiral inversion step in the metabolism of branched-chain fatty acids, ibuprofen and related drugs. Protein levels are increased in all prostate and some other cancer cells and it is used as a marker (P504S). The enzyme requires no cofactors and catalyzes its reaction by a stepwise 1,1-proton transfer via an enolate intermediate. The biological role of AMACR in cancer is complex, linking lipid metabolism with nuclear receptor (e.g. FXR and PPAR) activity and expression of enzymes such as cyclooxygenase-2 (COX-2). A number of rationally designed AMACR inhibitors have been reported in the literature as potential cancer treatments. The opportunities and challenges for development of acyl-CoA esters as inhibitors are discussed from a medicinal chemical viewpoint. Other challenges for drug development include the problems in assaying enzymatic activity and the prediction of structure-activity relationships (SAR). [PMID: 23376124]

WB result of AMACR Rabbit mAb
Primary antibody: AMACR Rabbit mAb at 1/500 dilution
Lane 1: LNCaP whole cell lysate 20 µg
Secondary antibody: Goat Anti-Rabbit IgG, (H+L), HRP conjugated at 1/10000 dilution
Predicted MW: 42kDa
Observed MW: 42kDa

Flow cytometric analysis of LNCaP cells labelling AMACR antibody at 1/250 (0.1 μg) dilution/ (red) compared with a Rabbit monoclonal IgG (Black) isotype control and an unlabelled control (cells without incubation with primary antibody and secondary antibody) (Blue). Goat Anti-Rabbit IgG Alexa Fluor® 488 was used as the secondary antibody.

IHC shows positive staining in paraffin-embedded human liver. Anti-AMACR antibody was used at 1/1000 dilution, followed by a HRP Polymer for Mouse & Rabbit IgG (ready to use). Counterstained with hematoxylin. Heat mediated antigen retrieval with Tris/EDTA buffer pH9.0 was performed before commencing with IHC staining protocol.

IHC shows positive staining in paraffin-embedded human prostate. Anti-AMACR antibody was used at 1/1000 dilution, followed by a HRP Polymer for Mouse & Rabbit IgG (ready to use). Counterstained with hematoxylin. Heat mediated antigen retrieval with Tris/EDTA buffer pH9.0 was performed before commencing with IHC staining protocol.

IHC shows positive staining in paraffin-embedded human colon cancer. Anti-AMACR antibody was used at 1/1000 dilution, followed by a HRP Polymer for Mouse & Rabbit IgG (ready to use). Counterstained with hematoxylin. Heat mediated antigen retrieval with Tris/EDTA buffer pH9.0 was performed before commencing with IHC staining protocol.

IHC shows positive staining in paraffin-embedded human lung adenocarcinoma. Anti-AMACR antibody was used at 1/1000 dilution, followed by a HRP Polymer for Mouse & Rabbit IgG (ready to use). Counterstained with hematoxylin. Heat mediated antigen retrieval with Tris/EDTA buffer pH9.0 was performed before commencing with IHC staining protocol.

IHC shows positive staining in paraffin-embedded human pancreatic carcinoma. Anti-AMACR antibody was used at 1/1000 dilution, followed by a HRP Polymer for Mouse & Rabbit IgG (ready to use). Counterstained with hematoxylin. Heat mediated antigen retrieval with Tris/EDTA buffer pH9.0 was performed before commencing with IHC staining protocol.

Negative control: IHC shows negative staining in paraffin-embedded human spleen. Anti-AMACR antibody was used at 1/1000 dilution, followed by a HRP Polymer for Mouse & Rabbit IgG (ready to use). Counterstained with hematoxylin. Heat mediated antigen retrieval with Tris/EDTA buffer pH9.0 was performed before commencing with IHC staining protocol.

IHC shows positive staining in paraffin-embedded mouse liver. Anti-AMACR antibody was used at 1/1000 dilution, followed by a HRP Polymer for Mouse & Rabbit IgG (ready to use). Counterstained with hematoxylin. Heat mediated antigen retrieval with Tris/EDTA buffer pH9.0 was performed before commencing with IHC staining protocol.

ICC shows positive staining in LNCaP cells. Anti-AMACR antibody was used at 1/250 dilution and incubated overnight at 4°C. Goat polyclonal Antibody to Rabbit IgG - H&L (Alexa Fluor® 488) was used as secondary antibody at 1/1000 dilution. The cells were fixed with 100% ice-cold methanol and permeabilized with 0.1% PBS-Triton X-100. Nuclei were counterstained with DAPI.